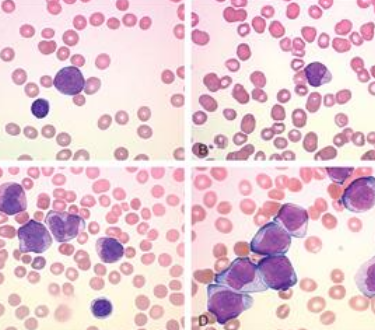

恩西地平可以用于治疗白血病M2。恩西地平是一种口服特异选择性IDH2抑制剂,通过抑制突变的IDH2,进而抑制2HG的产生,从而达到治疗肿瘤的目的。对于白血病M2(急性髓系白血病M2),如果伴有变异型IDH2,恩西地平可能是一个治疗选择。
恩西地平是一种口服特异选择性IDH2抑制剂,通过抑制突变的IDH2酶,降低2-HG的水平,恢复正常的细胞分化,抑制白血病细胞的生长,诱导白血病细胞的凋亡,以及逆转癌症相关的表观遗传改变。在临床试验中,恩西地平在急性髓系白血病中表现出色,疗效显著、安全性高。
恩西地平吃多久才起作用?
恩西地平(Idhifa/Enasidenib)在治疗白血病M2(急性髓系白血病M2)或其他相关类型的白血病时,其具体起效时间可能因个体差异、病情严重程度、治疗方案等多种因素而有所不同。
一般来说,恩西地平需要一定的时间来在患者体内积累并发挥作用。根据临床试验和患者的反馈,一些患者可能在开始治疗后的数周或数月内看到明显的疗效,包括症状的改善、疾病进程的减缓等。然而,也有一些患者可能需要更长的时间才能看到明显的治疗效果。